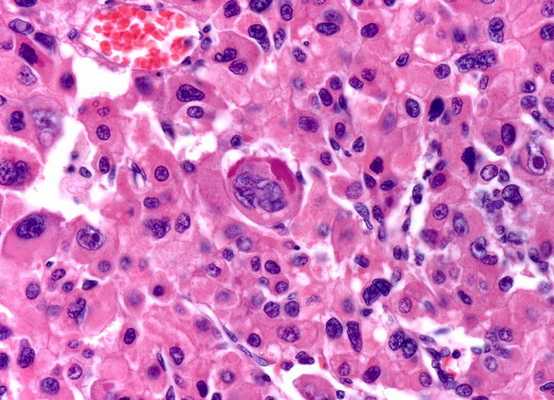
Промежуточные филаменты - значение в медицине

Значение белков связанных с промежуточными филаментами
Добавил пользователь Дмитрий К. Обновлено: 05.11.2025
Цитоплазма включает в себя гиалоплазму, мембранные и немембранные компоненты.
Гиалоплазма или матрикс цитоплазмы имеет вид тонкозернистого или гомогенного вещества с низкой электронной плотностью. Является сложной коллоидной системой, включающей в себя различные биополимеры: белки, нуклеиновые кислоты и т. д. Существует в двух состояниях: золеобразном (жидком) и гелеобразном. Отдельные зоны гиалоплазмы могут менять свое агрегатное состояние в зависимости от условий или от функциональной задачи. Так, известно, что отдельные молекулы белков-тубулинов могут быть диспергированы в гиалоплазме, но в определенные моменты они начинают собираться и строить длинные трубчатые структуры — микротрубочки. Этот процесс самосборки микротрубочек обратим: при изменении условий жизни клетки (повышение давления или изменение проницаемости мембран клетки) микротрубочки распадаются до мономерных молекул тубулинов. Таким же образом в бесструктурной на взгляд гиалоплазме могут возникать и распадаться различные фибриллярные, нитчатые комплексы белковых молекул.
В состав гиалоплазмы из микромолекул входят главным образом различные глобулярные белки и ферменты цитоплазматического матрикса. Они составляют 20‑25% общего содержания белков в эукариотической клетке. К важнейшим ферментам матрикса относятся ферменты гликолиза, ферменты метаболизма сахаров, азотистых оснований, аминокислот, липидов и других важных соединений. В матриксе располагаются ферменты активации аминокислот при синтезе белка, транспортные РНК. Осмотические и буферные свойства клетки в значительной степени определяются составом и структурой гиалоплазмы.
Роль гиалоплазмы заключается в том, что
1) она объединяет все клеточные структуры и обеспечивает химическое взаимодействие их друг с другом;
2) через нее осуществляется большая часть внутриклеточных транспортных процессов;
3) она является основным вместилищем АТФ;
4) в ней откладываются запасные продукты (гликоген, жировые капли).
К немембранным компонентам относят цитоскелет, клеточный центр и рибосомы.
Цитоскелет
Представляет собой сложную динамическую систему микротрубочек, микрофиламентов, промежуточных филаментов и микротрабекул. Каждый из этих компонентов образует в клетке трехмерную сеть, которая взаимодействует с сетями из других компонентов.
Основные функции цитоскелета:
‑ поддержание и изменение формы клетки;
‑ распределение и перемещение компонентов клетки;
‑ транспорт веществ в клетку и из нее;
‑ обеспечение подвижности клетки;
‑ участие в межклеточных соединениях.
Микротрубочки
Микротрубочки ‑ наиболее крупные компоненты цитоскелета. Они представляют собой полые цилиндрические образования, имеющие форму трубочек, длиной до нескольких микрометров (в жгутиках более 50 нм) диаметром около 24-25 нм, с толщиной стенки 5 нм и диаметром просвета 14-15 нм (рис.).

Стенка микротрубочки состоит из спиралевидно уложенных нитей ‑ протофиламентов толщиной 5 нм (которым на поперечном разрезе соответствуют 13 субъединиц), образованных димерами из белковых молекул α-и β-тубулина.
I Функции микротрубочек:
(1) поддержание формы и полярности клетки, распределения ее компонентов;
(2) обеспечение внутриклеточного транспорта;
(3) обеспечение движения ресничек, хромосом в митозе (формируют ахроматиновое веретено, необходимое для клеточного деления);
(4) образование основы других органелл (центриолей, ресничек).
Расположение микротрубочек. Микротрубочки располагаются в цитоплазме в составе нескольких систем:
а) в виде отдельных элементов, разбросанных по всей цитоплазме и формирующих сети;
б) в пучках, гдеони связаны тонкими поперечными мостиками (в отростках нейронов, в составе митотического веретена, манжетки сперматиды, переферического "кольца" тромбоцитов);
в) частично сливаясь друг с другом с формированием пар, или дублетов (в аксонеме ресничек и жгутиков), и триплетов (в базальном тельце и центриоли).
Образование и разрушение микротрубочек. Микротрубочки представляют собой лабильную систему, в которой имеется равновесие между их постоянной сборкой и диссоциацией. У большинства микротрубочек один конец (обозначаемый как "‑") закреплен, а другой ("+") свободен и участвует в их удлинении или деполимеризации. Структурами, обеспечивающими образование микротрубочек, служат особые мелкие сферические тельца ‑ сателлиты (от англ, satellite ‑ спутник), отчего последние называют центрами организации микротрубочек (ЦОМТ). Сателлиты содержатся в базальных тельцах ресничек и клеточном центре (см. рис.)

После полного разрушения микротрубочек в цитоплазме они отрастают от клеточного центра со скоростью около 1 мкм/мин., а их сеть вновь восстанавливается менее, чем за полтора часа. К ЦОМТ относят также и центромеры хромосом.
Угнетение самосборки микротрубочек посредством ряда веществ, являющихся ингибиторами митоза (колхицин, винбластин, винкристин), вызывает избирательную гибель быстро делящихся клеток. Поэтому некоторые из таких веществ успешно используются для химиотерапии опухолей. Блокаторы микротрубочек нарушают также транспортные процессы в цитоплазме, в частности, секрецию, аксонный транспорт в нейронах. Разрушение микротрубочек приводит к изменениям формы клетки и дезорганизации ее структуры и распределения органелл.
Микрофиламенты
Микрофиламенты ‑ тонкие белковые нити диаметром 5‑7 нм, лежащие в цитоплазме поодиночке, в виде сетей или пучками. В скелетной мышце тонкие микрофиламенты образуют упорядоченные пучки, взаимодействуя с более толстыми миозиновыми филаментами.
Под плазмолеммойнаходится густая сетьмикрофиламентов, характерная для большинства клеток. В этой сети микрофиламенты переплетены между собой и "сшиты" друг с другом с помощью особых белков, самым распространенным из которых является филамин. Кортикальная сеть препятствует резкой и внезапной деформации клетки при механических воздействиях и обеспечивает плавные изменения ее формы путем перестройки, которая облегчается актин-растворяющими ферментами.
Актин ‑ основной белок микрофиламентов ‑ встречается в мономерной форме (G-, или глобулярный актин), которая способна в присутствии цАМФ и Са 2 + полимеризоваться в длинные цепи (F-, или фибриллярный актин). Обычно молекула актина имеет вид двух спирально скрученных нитей.

В микрофиламентах актин взаимодействует с рядом актин-связывающих белков (до нескольких десятков видов), выполняющих различные функции. Некоторые из них регулируют степень полимеризации актина, другие способствуют связыванию отдельных микрофиламентов в системы. В не мышечных клетках на актин приходится примерно 5‑10% содержания белка, лишь около половины его организовано в филаменты. Микрофиламенты более устойчивы к физическим и химическим воздействиям, чем микротрубочки.
Функции микрофиламентов:
(1) обеспечение сократимости мышечных клеток (при взаимодействии с миозином);
(2) обеспечение функций, связанных с кортикальным слоем цитоплазмы и плазмолеммой (экзо- и эндоцитоз, образование псевдоподий и миграция клетки);
(3) перемещение внутри цитоплазмы органелл, транспортных пузырьков и других структур благодаря взаимодействию с некоторыми белками (минимиозином), связанными с поверхностью этих структур;
(4) обеспечение определенной жесткости клетки за счет наличия кортикальной сети, которая препятствует действию деформаций, но сама, перестраиваясь, способствует изменениям клеточной формы;
(5) формирование сократимой перетяжки при цитотомии, завершающей клеточное деление;
(6) образование основы ("каркаса") некоторых органелл (микроворсинок, стереоцилий).
(7) участие в организации структуры межклеточных соединений (опоясывающих десмосом).
Актиновые микрофиламенты образуют основу микроворсинок ‑ пальцевидные выросты цитоплазмы клетки диаметром 0.1 мкм и длиной 1 мкм. Микроворсинки обеспечивают многократное увеличение площади поверхности клетки, на которой происходит расщепление и всасывание веществ. На апикальной поверхности некоторых клеток, активно участвующих в указанных процессах (в эпителии тонкой кишки и почечных канальцев) имеется до нескольких тысяч микроворсинок, образующих в совокупности щеточную каемку. Каркас каждой микроворсинки образован пучком, содержащим около 40 микрофиламентов, лежащих вдоль ее длинной оси (рис. ).

В апикальной части микроворсинки этот пучок закреплен в аморфном веществе. Его жесткость обусловлена поперечными сшивками из белков фимбрина и виллина, изнутри пучок прикреплен к плазмолемме микроворсинки особыми белковыми мостиками (молекулами минимиозина). У основания микроворсинки микрофиламенты пучка вплетаются в терминальную сеть, среди элементов которой имеются миозиновые филаменты. Взаимодействие актиновых и миозиновых филаментов терминальной сети, вероятно, обусловливает тонус и конфигурацию микроворсинки.
Промежуточные филаменты
Промежуточные филаменты ‑ прочные и устойчивые в химическом отношении белковые нити толщиной около 10 нм (что является промежуточным значением между толщиной микротрубочек и микрофиламентов). Они встречаются в клетках разных тканей (см. ниже) и располагаются в виде трехмерных сетей в различных участках цитоплазмы, окружают ядро, входят в состав десмосом и полудесмосом эпителиальных клеток (в плазмолемме которых они закреплены посредством трансмембранных белков), лежат по всей длине отростков нейронов. Промежуточные филаменты образованы нитевидными белковыми молекулами, сплетенными друг с другом наподобие каната.

Функции промежуточных филаментов изучены недостаточно; установлено, однако, что они не влияют ни на движение, ни на деление клетки. К их основным функциям относятся:
(1) структурная ‑ поддерживающая и опорная, обеспечение распределения органелл по определенным участкам цитоплазмы;
(2) обеспечение равномерного распределения сил деформации между клетками ткани, что препятствует повреждению отдельных клеток (благодаря связи промежуточных филаментов с трансмембранными белками десмосом и полудесмосом);
(3) участие в образовании рогового вещества в эпителии кожи; в эпителиальных клетках связываются с другими белками и образуют непроницаемые барьеры (роговые чешуйки), являются главным компонентом волос и ногтей;
(4) поддержание формы отростков нервных клеток и фиксация трансмембранных белков (в частности, ионных каналов);
(5) удержание миофибрилл в мышечной ткани и прикрепление их к плазмолемме, что обеспечивает их сократительную функцию.
В поврежденной клетке сеть промежуточных филаментов (в отличие от других компонентов цитоскелета) спадается и концентрируется вокруг ядра, связывая поврежденные органеллы и белковые агрегаты. Формируется своеобразная структура, которая наподобие кокона концентрирует поврежденные компоненты клетки для последующего уничтожения путем их внутриклеточного переваривания. В ходе восстановления структуры и функции клетки после повреждения сеть промежуточных филаментов вновь развертывается по всей цитоплазме. В отличие от микрофиламентов и микротрубочек, для образования промежуточных филаментов не требуется АТФ, причем они не подвергаются постоянной сборке и диссоциации, а представляют собой менее лабильные и сравнительно устойчивые структуры.
Несмотря на то, что строение промежуточных филаментов в клетках различных типов сходно, они существенно различаются по своей молекулярной массе и химической природе, что может быть продемонстрировано иммуноцитохимическими методами с антителами к промежуточным филаментам различных классов.
Различают 6 основных классов промежуточных филаментов: кератиновые (эпителиальные ткани), десминовые (мышечные ткани), виментиновые (клетки мезенхимного происхождения - фибробласты, макрофаги, остеобласты и т.д.), нейрофиламенты (нейроны), глиальные (астроциты, олигодендроциты), ламины (во всех клетках, образуют кариоскелет).
Идентификация классов промежуточных филаментов имеет важное значение в диагностике опухолей для выявления тканевой принадлежности опухолевых клеток, что может определить выбор лечения и прогноз. Наибольшее диагностическое значение имеет выявление цитокератинов, десмина и глиального фибриллярного кислого белка, которые служат маркерами опухолей эпителиального, мышечного и глиального происхождения. Менее отчетливые результаты дает обнаружение виментина, который экспрессируется и коэкспрессируется (экспрессируется в сочетании с белками других классов промежуточных филаментов) многими типами клеток. Существенную информацию о степени поражения эпителия можно получить путем определения экспрессии молекулярных форм кератинов, специфичных для клеток конкретной локализации и уровня дифференпировки. Таким путем можно установить, например, ранние предраковые изменения в эпителии, не выявляемые стандартными морфологическими методами.
Микротрабекулы
Микротрабекулы ‑ наименее изученная система цитоскелета, само существование которой оспаривается многими исследователями. Предполагают, что три описанные выше системы филаментов пронизываются и объединяются некоей четвертой системой, названной микротрабекулярной сетью. Последняя выявляется при высоковольтной электронной микроскопии как система нитей неравномерной толщины (2‑10 нм), связывающая три системы цитоскелета, различные органеллы и плазмолемму. В "узлах" микротрабекулярной сети располагаются свободные рибосомы и полисомы. Белок, образующий микротрабекулярную сеть, не идентифицирован. Высказываются предположения о том, что эта сеть представляет собой артефакт, возникающий в результате преципитации и коагуляции белков при фиксации цитоплазмы клетки.
Почему человек чувствует себя несчастным?: Для начала определим, что такое несчастье. Несчастьем мы будем считать психологическое состояние.
Промежуточные филаменты.
Эта сложная система цитоскелетных нитей изучена относительно недавно. Белки промежуточных филамен- тов обладают сходным строением и построены по общему принципу. Они образованы из двух или трех разных белков, образующих скрученную спираль. Молекулы имеют удлиненную форму и содержат длинный а-спиральный центральный участок, ограниченный линейными головными и хвостовыми участками. Все они собираются в филаменты, диаметр которых около 10 нм. Молекулярная масса большинства белков промежуточных филаментов находится между 40 и 70 кД. Они не подвергаются постоянной сборке и разборке, а представляют собой сравнительно устойчивые цитоскелетные структуры. Важной особенностью промежуточных филаментов является их способность к самосборке без дополнительных источников энергии в виде энергии гидролиза ГТФ или АТФ.
Оказалось, что, в отличие от микротрубочек и актиновых филаментов, промежуточные филаменты построены в разных клетках из разных белков (рис. 3.18).
Выделяют шесть основных типов промежуточных филаментов (табл. 3.3). Они выполняют в клетках те же функции, которые характерны для других компонентов цитоскелета. Но их открытие и изучение имело чрезвычайно важные последствия для молекулярной биологии и медицины. Как видно из табл. 3.3, в разных клетках промежуточные филаменты построены из разных белков, а тубулины и актины у всех одинаковые. Более того, белки из ткани определенного типа у разных организмов более сходны, чем разные филаменты в тканях одного организма. При изменении формы, свойств и даже местоположения клеток в организме белки промежуточных филаментов сохраняются, определяя принадлежность клетки к определенному типу. Это постоянство очень важно для диагностики опухолей разного вида. Дело в том, что при перерождении клетки в раковую, она теряет многие черты своей изначальной организации и определить тип опухоли очень трудно. Но белки промежуточных филаментов остаются такими же, какими были в изначальной ткани. Исследуя белки филаментов в опухолевых клетках, можно точно определить, клетки какой ткани дали начало этой опухоли. Это правило распространяется и на метастазы опухолей, которые могут распространяться далеко от места первоначального образования опухолей. 1

Рис. 3.18. Цитоскелет клетки. Промежуточные филаменты (строение, сборка, расположение в клетке):
А — схема сборки филементов; Б — микрофотография расположения сети промежуточных филатентов в клетке (иммуногистохимия, световой микроскоп): 1 — мономеры; 2 — димеры; 3 — тетрамеры; 4 — протофибриллы; 5 — зрелый промежуточный филамент; 6 — ядро эпителиальной клетки; 7 — сеть кератиновых филаментов в цитоплазме клетки [1]
Состав и принадлежность к определенным типам клеток и тканей промежуточных филаментов цитоскелета животных клеток
Класс промежуточных филаментов
Кератины (более 20 белков)
Клети покровного и кишечного эпителия. Другие виды эпителиев
В мышечных клетках (кроме гладких миоцитов)
В клетках соединительной ткани, хряща, кости, железах, эндотелии сосудов и гладких миоцитах
Глиальный кислый фибриллярный белок
В клетках глии нервной системы
В нервных клетках
Ламины (несколько белков)
Во всех клетках. Расположены в ядре клеток, образуя так называемую ядерную пластинку.
Цитоскелет прокариотической клетки. Долгое время считалось, что в бактериальной клетке нет элементов цитоскелета, однако в начале 1990-х гг. было установлено, что эубактерии и археи содержат элементы цитоскелета, гомологичные по составу и функции цитоске- летным белкам эукариот.
В 2001 г. у бактерии Bacillus subtilis были обнаружены белки — гомологи актина: МгеВ (англ, murein cluster В) и РагМ (англ, partitioning motor), которые формируют в клетке длинные фибриллы. Одной из основных функций белка МгеВ является поддержание палочкоподобной или спиральной формы бактериальной клетки. Однако, в отличие от цитоскелетных белков в эукариотической клетке, они не служат непосредственно каркасом для поддержания формы клетки, а являются местами для прикрепления ферментов, синтезирующих компоненты клеточной стенки бактерии, которая и определяет форму бактериальной клетки. Филаменты, образованные МгеВ, постоянно собираются и разбираются. Показано, что белки МгеВ участвуют в делении бактериальной клетки, концентрируясь в районе перетяжки.
Фибриллы из белка РагМ также постоянно собираются и разбираются в цитоплазме бактерий и состоят из двух протофиламентов, закрученных друг вокруг друга наподобие спирали F-актина. В клетках мономеры РагМ формируют длинные неразветвленные филаменты, которые служат для прикрепления плазмид и их распределения по полюсам клетки при делении.
У большинства эубатерий и архей обнаружен и гомолог тубулина — белок FtsZ, состоящий из двух субъединиц и формирующий филаменты, которые напоминают протофиламенты микротрубочек и обладают ГТФ-азной активностью. В бактериях эти филаменты образуют так называемое Z-колыдо в зоне перетяжки бактерии при ее делении. Еще один гомолог тубулина — белок BtubA/B обнаружен у бактерий из рода Prosthecobacter.
В составе цитоскелета бактерий было обнаружено еще несколько белков: семейство филаментозных белков Min (MinC, MinD, MinE), MamK, бактофилин, кренактин и ряд других. Все они в той или иной степени принимают участие в поддержании формы бактериальной клетки и в процессе деления.
Таким образом, цитоплазма и цитоскелет — это не застывшая, пассивная субстанция, а активная часть клетки, все время изменяющая свою структуру и приспосабливающаяся к постоянно меняющимся условиям внутренней и внешней среды.
Промежуточные филаменты
- это тонкие (10 нм) неветвящиеся, часто располагающиеся пучками нити. Характерно, что их белковый состав различен в разных тканях. Содержатся как в цитоплазме, так и в ядре большинства эукариотических клеток.
113.классификация.Существует пять ткане-специфических классов белков промежуточных филаментов : виментин , десмин , глиальный фибриллярный кислый белок ,белки нейрофиламентов и кератины. Недавно в семейство белков промежуточных филаментов включили ламины - белки, образующие скелет ядерной оболочки на внутренней стороне мембраны.
§ Ваментиновые филаменты - в клетках мезенхимного происхождения;
§ десминовые ф.- гладкая и поперечно-полосатая мышечная ткань;
§ глиальный фибриллярный кислый белок - клетки глии (сложный комплекс вспомогательных клеток нервной ткани);
§ белки нейрофиламентов - нервные клетки;
§ кератиновые ф.- эпителиальная ткань;
§ ламины - ядерная пластинка.
Ультраструктура и молекулярная организация промежуточных филаментов.
Жизненный цикл клетки (клеточный цикл)
- это время существования клетки от деления до следующего деления, или от деления до смерти. Для разных типов клеток клеточный цикл различен.
Митотический цикл -существование клетки от деления до следующего деления.
Пресинтетическая, синтетическая и постсинтетическая фазы.
Интерфаза - это период между двумя клеточными делениями. В интерфазе ядро компактное, не имеет выраженной структуры, хорошо видны ядрышки. Совокупность интерфазных хромосом представляет собой хроматин. Хромосомы в интерфазе не видны, поэтому их изучение ведется электронно-микроскопическими и биохимическими методами. Интерфаза включает три стадии: пресинтетическую (G1), синтетическую (S) и постсинтетическую (G2). G1-фаза — самый длительный период (от 10 ч до нескольких суток). Заключается в подготовке клеток к удвоению хромосом. Сопровождается синтезом белков, РНК, увеличивается количество рибосом, митохондрий. В этой фазе происходит рост клетки. S-фаза (6—10 ч) - происходит самоудвоение, или репликация ДНК. При этом одни участки хромосом удваиваются раньше, а другие - позже, то есть репликация ДНК протекает асинхронно. Параллельно происходит удвоение центриолей (если они имеются). G2-фаза (3—6 ч) — сопровождается конденсацией хромосом. В течение указанной фазы синтезируются белки микротрубочек, формирующих веретено деления.
Митоз
- непрямое деление соматических клеток эукариотов. Идёт глубокая перестройка структуры клеток. Митоз приводит к образованию двух полноценных клеток с диплоидным набором хромосом и равномерно распределенном клеточным материалом. Клеточный цикл может совпадать или не совпадать с митотическим. Если клеточный цикл совпадает с митотическим, то он состоит из митоза и интерфазы.
Как выбрать специалиста по управлению гостиницей: Понятно, что управление гостиницей невозможно без специальных знаний. Соответственно, важна квалификация.
Модели организации как закрытой, открытой, частично открытой системы: Закрытая система имеет жесткие фиксированные границы, ее действия относительно независимы.
Как вы ведете себя при стрессе?: Вы можете самостоятельно управлять стрессом! Каждый из нас имеет право и возможность уменьшить его воздействие на нас.
Промежуточные филаменты: описание, структура, функции и особенности
Промежуточные филаменты - характерная структура эукариотических клеток. Они обладают способностью к самосборке и являются химически устойчивыми. Строение и функции промежуточных филаментов определяются особенностями связей в белковых молекулах. Они служат не только для формирования клеточного каркаса, но и обеспечивают взаимодействие органелл.
Общее описание

Филаменты - это белковые структуры нитчатого вида, которые принимают участие в построении цитоскелета. В соответствии с диаметром их делят на 3 класса. Промежуточные филаменты (ПФ) имеют среднюю величину в поперечном разрезе - 7-11 нм. Они занимают промежуточное положение между микрофиламентами Ø5-8 нм и микротрубочками Ø25 нм, за что и получили свое название.
Различают 2 типа этих структур:
- Ламиновые. Они находятся в ядре. Ламиновые филаменты есть у всех животных.
- Цитоплазматические. Располагаются в цитоплазме. Имеются у нематод, моллюсков, позвоночных. У последних в некоторых видах клеток могут отсутствовать (например, в глиальных клетках).
Местонахождение

Промежуточные филаменты являются одним из основных элементов цитоскелета живых организмов, клетки которых содержат ядра (эукариоты). У прокариотов также встречаются аналоги этих фибриллярных структур. В клетках растений они не найдены.
Большая часть филаментов находится в околоядерной зоне и пучках фибрилл, которые располагаются под плазматической мембраной и отходят от центра к краям клеток. Особенно их много в тех видах, которые подвергаются механическим нагрузкам - в мышечных, эпителиальных, а также в клетках нервных волокон.
Типы белков

Как показывают исследования, белки, входящие в состав промежуточных филаментов, различают в зависимости от вида клеток и стадии их дифференцировки. Однако все они являются родственными.
Белки промежуточных филаментов делят на 4 типа:
- Кератины. Они образуют полимеры из двух подтипов - кислых и нейтральных. Молекулярная масса этих соединений колеблется в интервале 40 000-70 000 а. е. м. В зависимости от тканевого источника число разнообразных гетерогенных форм кератинов может достигать нескольких десятков. Их подразделяют на 2 группы по изоформе - эпителиальные (наиболее многочисленные) и роговые, из которых состоят волосы, рога, ногти и перья животных.
- Во втором типе объединяют 3 вида белков, имеющих практически одинаковую молекулярную массу (45 000-53 000 а. е. м.). К ним относятся: виментин (соединительная ткань, плоские клетки, выстилающие поверхность кровеносных и лимфатических сосудов; клетки крови); десмин (мышечная ткань); периферин (периферические и центральные нейроны); глиальный фибриллярный кислый протеин (высоко специфичный белок мозга).
- Белки нейрофиламентов, встречающиеся в нейритах - цилиндрических отростках, по которым проходят импульсы между нервными клетками.
- Белки ядерной ламины, подстилающей ядерную мембрану. Они являются предшественниками всех остальных ПФ.
Промежуточные филаменты могут состоять из нескольких видов вышеперечисленных веществ.
Свойства
Характеристики ПФ определяются следующими их особенностями:
- большое число полипептидных молекул в поперечном сечении;
- сильные гидрофобные взаимодействия, играющие важную роль в сборке макромолекул по типу скрученной суперспирали;
- образование тетрамеров с высоким электростатическим взаимодействием.
В результате промежуточные филаменты приобретают свойства прочного скрученного каната - они хорошо гнутся, но не рвутся. При обработке реагентами и сильными электролитами эти структуры последними переходят в раствор, то есть для них характерна высокая химическая стабильность. Так, после полной денатурации белковых молекул в мочевине филаменты могут самостоятельно собираться. Белки, привнесенные извне, быстро встраиваются в уже существующую структуру данных соединений.
Структура

По своему строению промежуточные филаменты представляют собой неветвящиеся полимеры, которые способны как к образованию высокомолекулярных соединений, так и к деполимеризации. Их структурная неустойчивость помогает клеткам изменять свою форму.
Несмотря на то что филаменты имеют разнообразный состав по типу белков, у них существует один и тот же план строения. В центре молекул находится альфа-спираль, имеющая форму правозакрученной винтовой линии. Она образована за счет контактов между гидрофобными структурами. В ее структуре находятся 4 спиральных сегмента, разделенных короткими не спиральными участками.
На концах альфа-спирали расположены домены с неопределенной структурой. Они играют важную роль в сборке филаментов и взаимодействии с клеточными органеллами. Их размеры и белковая последовательность сильно варьируются среди разных видов ПФ.
Строительный белок
Основным строительным материалом для ПФ являются димеры - сложные молекулы, составленные из двух простых. Обычно они включают 2 разных белка, соединенных между собой палочковидными структурами.
Цитоплазматический тип филаментов состоит из димеров, которые образуют нити толщиной в 1 блок. Так как они расположены параллельно, но в противоположном направлении, то полярность отсутствует. Из этих димерных молекул впоследствии могут сформироваться более сложные.
Функции

Основными функциями промежуточных филаментов являются следующие:
- обеспечение механической прочности клеток и их отростков;
- адаптация к стрессовым факторам;
- участие в контактах, обеспечивающих прочное соединение клеток (эпителиальная и мышечная ткань);
- внутриклеточное распределение белков и органелл (локализация аппарата Гольджи, лизосом, эндосом, ядер);
- участие в транспортировке липидов и передаче сигналов между клетками.
ПФ также оказывают влияние на функции митохондрий. Как показывают лабораторные эксперименты на мышах, у тех особей, которые лишены гена десмина, нарушается внутриклеточное расположение этих органелл, а сами клетки запрограммированы на меньший срок жизни. В результате снижается потребление кислорода тканями.
С другой стороны, присутствие промежуточных филаментов способствует снижению подвижности митохондрий. Если в клетку ввести искусственно виментин, то можно восстановить сеть ПФ.
Значение в медицине
Нарушения синтеза, накопления и структуры ПФ приводит к возникновению некоторых патологических состояний:
Глиальный фибриллярный кислый белок ( аутоиммунитет)
Опухолевые или аутоиммунные заболевания и связанные с ними нейронные антитела не являются здесь редкостью. Ответ на стероиды является обычным явлением, хотя были описаны рецидивирующие случаи и редкие фатальные последствия. Согласно Fang et al. более трети случаев аутоиммунного менингоэнцефаломиелита GFAP связаны с неоплазией, иногда с продемонстрированным паранеопластическим механизмом.
Низкая чувствительность анализа сыворотки крови при аутоиммунной астроцитопатии может быть связана с интратекальным синтезом антител, тогда как его низкая специфичность может объяснить клиническую гетерогенность аутоиммунитета GFAP. Рекомендуется обнаружение GFAP-Ab в спинномозговой жидкости с помощью непрямой иммунофлуоресценции на тканях мозга крыс и клеточных анализов (IFA и CBA) с использованием GFAPα.
Прогрессирующая мультифокальная лейкоэнцефалопатия была заподозрена у некоторых пациентов с положительной ПЦР на вирус CSF JC. Следовательно, возможно, что вирус JC вызвал аутоиммунитет GFAP или что токсичность вируса JC по отношению к астроцитам просто демаскировала экспрессию GFAP, индуцируя секрецию антител против GFAP без собственных клинических последствий. Поскольку уже сообщалось об антителах к GFAP при опухолях головного мозга (астроцитоме), точный механизм аутоиммунитета GFAP при прямых повреждениях ЦНС является предметом дискуссий. Таким образом, рекомендуется искать альтернативное неврологическое расстройство в случаях с атипичным фенотипом или плохим ответом на иммунотерапию.
Читайте также:
- Интерпретация страданий трудных больных. Диагноз мнимого больного
- Плазмоцитома сосудистой оболочки глаза: признаки, гистология, лечение, прогноз
- Стрессовое расстройство (острая реакция на стресс)
- Акт дефекации. Опорожнение кишечника. Рефлекс дефекации. Стул.
- Различия рака и туберкуломы. Диагностические особенности рака и туберкуломы.
